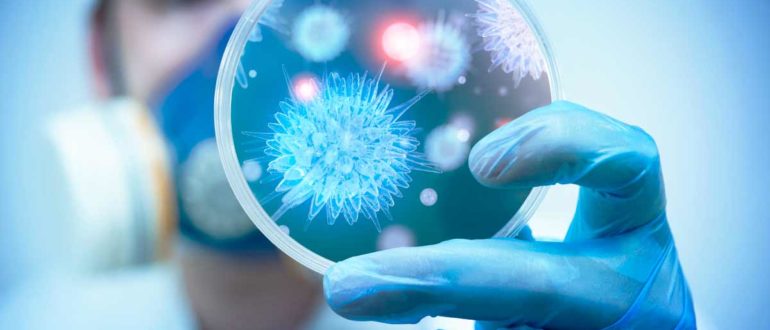

Разное
Думаю, что каждая семья ощутила, как меняется характер у мамы, сестры или дочери в определенные дни месяца. Предменструальный синдром (ПМС) называют «предменструальной болезнью» или «циклическим синдромом». Предменструальный синдром
Даже дети знают, что во время пандемии мы должны соблюдать правила личной гигиены и социальную дистанцию, подробнее http://med-arhiv.com/. Но долгое пребывание дома может плохо сказаться на нашем организме.
Абстинентным синдромом называют состояние после отказа от алкоголя при постоянном его употреблении. То есть, если резко перестать принимать алкогольные напитки, то может возникнуть абстиненция. Врачи проводят купирование абстинентного
Да-да, у природы не бывает плохой погоды. А ее капризы – это часть сезонных преобразований, с которыми человек сталкивается ежегодно. Как будет меняться самочувствие у метеочувствительных людей, и
На протяжении веков люди по всему миру полагались на традиционную травяную медицину для удовлетворения своих медицинских потребностей. Несмотря на медицинские и технологические достижения современной эпохи, мировой спрос на
Алкоголизм определяется как поведенческое расстройство, девиантная форма поведения, которая возникает в результате длительного употребления чрезмерного количества алкоголя. Причина алкоголизма остается неизвестной, но определенные черты характера присутствуют в большом
Традиционно в последние дни ноября в России отмечают День Матери. Праздник, который напоминает о самых дорогих людях в жизни. Так хочется позвонить маме, приехать к ней, подарить красивые
Во многих отношениях хорьки действуют как котята, которые никогда не вырастут. У них есть энергия, любопытство и желание играть на протяжении всей жизни, и они всегда понимают реакцию
В соответствии с устоявшимся мнением, мужчины больше представительниц слабого пола подвержены ипохондрическим настроениям. Зачастую это соответствует действительности, но, как ни парадоксально, боязнь болезней прекрасно уживается с отсутствием желания
С развитием медицины, диетологии и спорта изменилось в лучшую сторону отношение к здоровью и телу в сознании человека. Люди ведут правильный образ жизни, стараясь предупредить болезни и улучшить